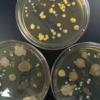

| ||||
Bacterial Colony Morphology & Bacterial ID - P3
Tiny, punctiform, creamy white bacterial colonies characteristic of Staphylococcus, growing on Mannitol Salt Agar (MSA).
SCIENCE PHOTOS
Page last updated: 3/2016
SPO VIRTUAL CLASSROOMS
1. Normal flora from the arm; 2. obtained using an "arm plate; 3. Touch plates growing bacteria from the fingertips; 4 & 5, Various Gram-negative bacterial colonies growing on MacConkey's agar. Photos from the SPO Bacterial Media & Culture Laboratory Exercise.
Additional Sources and Resources
- Leboffe, M. J. and Pierce, B. E. (2010) Microbiology Laboratory Theory and Application, Third Edition. Morton Publishing Company.
- Bauman, R. (2014) Microbiology with Diseases by Taxonomy 4th ed., Pearson Benjamin Cummings.
- Colony Morphology: Describing Bacterial Colonies PDF document from Rutgers.
- Photo Gallery of Bacterial Colonies from BacteriaInPhotos.com.
Free Educational Materials on Identifying Bacteria
- Identifying Bacteria Lab Exercise Main Page.
- Bacterial Growth Media Images from SPO.
PAGE 3 < Back to Page 2
End of Article
Additional Photos of Bacterial Colonies
(Click on strip to enlarge).
You have free access to a large collection of materials used in two college-level introductory microbiology courses (8-week & 16-week). The Virtual Microbiology Classroom provides a wide range of free educational resources including PowerPoint Lectures, Study Guides, Review Questions and Practice Test Questions.